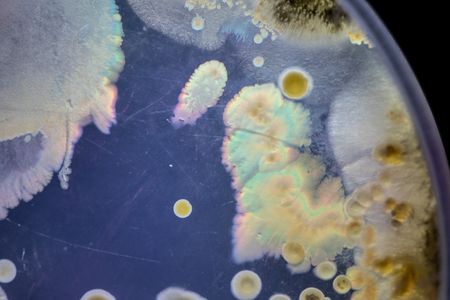
Mold Beautiful, Colony of Characteristics of Fungus (Mold) in culture medium plate from laboratory microbiology.の写真素材

写真素材 - Mold Beautiful, Colony of Characteristics of Fungus (Mold) in culture medium plate from laboratory microbiology.
作品情報
Mold Beautiful, Colony of Characteristics of Fungus (Mold) in culture medium plate from laboratory microbiology.
- ID:123737344
- 作品種別:写真
- 作者名:sinhyu
キーワード
- abstract
- allergy
- antibiotic
- ascomycetous
- aspergillus
- background
- bacteria
- biological
- biology
- black
- bread
- cells
- closeup
- colony
- corrosion
- culture
- detail
- disease
- drug
- education
- food
- fungal
- fungi
- fungus
- green
- growth
- health
- healthcare
- hygiene
- hyphae
- infection
- infectious
- isolated
- lab
- laboratory
- life
- macro
- medicine
- micro
- microbe
- microbes
- microbial
- microbiology
- microscope
- microscopic
- mildew
- mold
- moldy
- mould
- mycelium
- mycology
- mycosis
- organic
- pencil-like
- penicillium
- petri
- plate
- research
- rotten
- rotting
- round
- science
- scientific
- spoiled
- spore
- spores
- test
- texture
- white
- yeast
類似作品
Green mould bac...
A close-up, mac...
Ants macro aliv...
fungus on rot f...
Mold and fungus...
Abstract fracta...
Close up of lic...
Mold and fungus...
macro Seeds and...
Mold Beautiful,...
A close-up view...
Mold and fungus...
Soap foam with ...
Contemporary Se...
Mold on the whi...
Mold and fungus...
A macro shot of...
Mold and fungus...
A close-up of c...
This macro imag...
Pumpkin covered...
Close-up view o...
Close view of c...
Mold on food Fr...
Mold and fungus...
Surface with ge...
Mold and fungus...
Fern growing in...
Winter scenery ...
This close-up o...
Beach of Etreta...
Mold and fungus...
black mold on w...
Explore the mes...
Coffee foam tex...
Black mold on w...
Variety of natu...
Moss-covered st...
Natural texture...
Dying variable ...
close-up of bac...
A close-up, mac...
Bubbles on a wo...
Close-up view o...
Top-down view o...
Close-up of a r...
Mold and fungus...
surface of craf...
Mold and fungus...